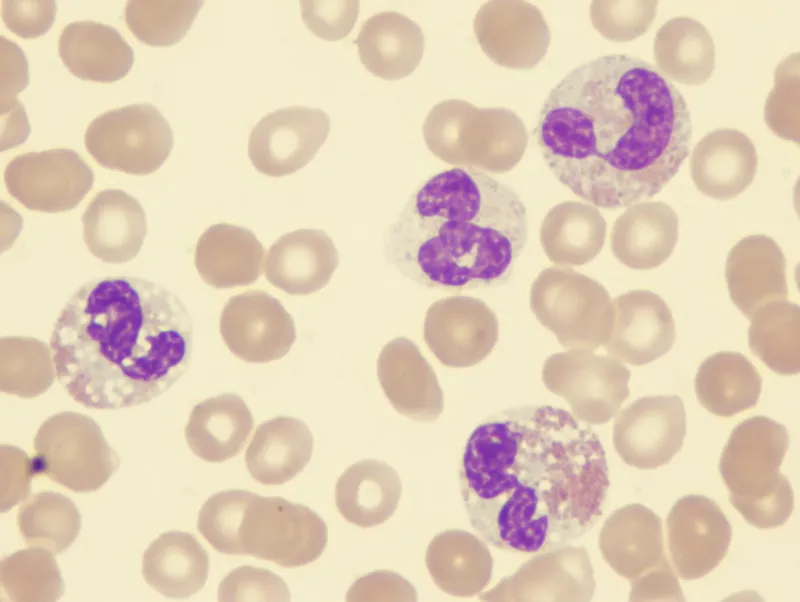
Dysplastic neutrophils in myelodysplastic syndrome

MDS Overview - Marrow Mayhem
- Clonal disorders of hematopoietic stem cells, primarily affecting the elderly.
- Leads to "marrow failure":
- Ineffective hematopoiesis: marrow is active but produces defective, dysplastic cells.
- Results in peripheral blood cytopenias (e.g., anemia, neutropenia, thrombocytopenia).
- Hallmark: Morphologic dysplasia in ≥1 myeloid lineage (erythroid, granulocytic, megakaryocytic).
- Variable risk of progression to Acute Myeloid Leukemia (AML).
⭐ MDS is a clonal hematopoietic stem cell disorder characterized by ineffective hematopoiesis and a variable risk of transformation to acute myeloid leukemia (AML).
Etiology & Pathogenesis - Genesis of Grief
- Primary (De Novo) MDS: Most common (~80%); idiopathic, age-related.
- Secondary MDS:
- Therapy-related (t-MDS): Alkylating agents (5-7 yrs, -5/del(5q), -7/del(7q)), Topo II inhibitors (1-3 yrs, 11q23).
⭐ Therapy-related MDS (t-MDS), often associated with prior exposure to alkylating agents or topoisomerase II inhibitors, typically carries a poorer prognosis and distinct cytogenetic abnormalities like -5/del(5q) or -7/del(7q).
- Environmental: Benzene, radiation.
- Inherited: Fanconi anemia.
- Therapy-related (t-MDS): Alkylating agents (5-7 yrs, -5/del(5q), -7/del(7q)), Topo II inhibitors (1-3 yrs, 11q23).
- Pathogenesis:
- Clonal HSC disorder: Somatic mutations (e.g., TET2, SF3B1, TP53).
- Ineffective hematopoiesis: ↑ Apoptosis → cytopenias.
- Epigenetic dysregulation & immune dysfunction.
WHO Classification & Features - Dysplasia Directory
WHO 2022 classifies MDS based on blast counts, dysplasia, and cytogenetics. Key categories:
- MDS with Low Blasts (MDS-LB):
- Includes Single Lineage (SLD) & Multilineage Dysplasia (MLD).
- MDS with SF3B1 mutation (MDS-SF3B1).
⭐ MDS-RS: strong SF3B1 association; ≥15% ring sideroblasts (RS) in erythroid precursors (or ≥5% RS if SF3B1 mutated).
- MDS with Increased Blasts (MDS-IB):
- MDS-IB1: BM blasts 5-9%; PB blasts 2-4%.
- MDS-IB2: BM blasts 10-19%; PB blasts 5-19%. (≥20% blasts = AML).
- MDS with del(5q): Isolated del(5q), blasts <5%.
- MDS, Hypoplastic (MDS-h)
- MDS with biallelic TP53 inactivation (MDS-biTP53)
- MDS, Unclassifiable (MDS-U)
Dysplasia (≥10% of cells in a lineage):
- Erythroid: Megaloblastoid changes, nuclear budding/irregularities, ring sideroblasts.
- Granulocytic (Myeloid): Pseudo-Pelger-Huët (bilobed/hypolobated nuclei), hypogranulation.
- Megakaryocytic: Micromegakaryocytes, monolobed/bilobed or multiple separated nuclei.

Diagnosis, Prognosis & Management Snippets - Spot, Score, Strategize
- Diagnosis "Spot":
- CBC: Persistent cytopenia(s).
- Peripheral Smear: Dysplastic features (Pelger-Huët like cells).
- Bone Marrow Aspirate & Biopsy: Hypercellular (often), dysplasia in ≥10% cells of ≥1 lineage; BM blasts <20%.
- Cytogenetics: Essential (e.g., del(5q), -7/monosomy 7, +8/trisomy 8).
- Prognosis "Score":
- IPSS-R: Stratifies risk (Very Low to Very High).
⭐ The Revised International Prognostic Scoring System (IPSS-R) for MDS incorporates bone marrow blast percentage, karyotype, and depth of cytopenias (hemoglobin, platelet count, absolute neutrophil count) to stratify patients into risk categories.
- IPSS-R: Stratifies risk (Very Low to Very High).
- Management "Strategize" (Risk-Adapted):
- Lower-Risk (LR-MDS):
- Supportive: Transfusions, Erythropoiesis-Stimulating Agents (ESAs), G-CSF.
- Specific: Lenalidomide (for del(5q)), Luspatercept (for MDS-RS).
- Higher-Risk (HR-MDS):
- Hypomethylating Agents (HMAs): Azacitidine, Decitabine.
- Allogeneic Stem Cell Transplant (allo-SCT): Only curative option.
- Lower-Risk (LR-MDS):
High‑Yield Points - ⚡ Biggest Takeaways
- Ineffective hematopoiesis leads to peripheral cytopenias despite a hypercellular bone marrow.
- Dysplastic changes in one or more myeloid cell lines are characteristic.
- MDS carries a significant risk of transformation to Acute Myeloid Leukemia (AML).
- Del(5q) is a key cytogenetic abnormality, often associated with a good prognosis.
- Ring sideroblasts (abnormal iron) are key in MDS-RS.
- Bone marrow shows <20% blasts; >20% defines AML.
- Predominantly a disease of the elderly.
Unlock the full lesson and continue reading
Signup to continue reading this lesson and unlimited access questions, flashcards, AI notes, and more